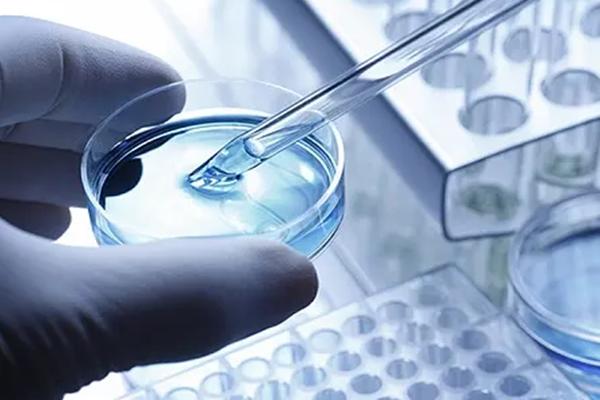
2023俄罗斯单身试管婴儿费用公开，附助孕成功率、流程介绍

时间:2023-11-07 分类: 试管资讯 查看: 133
近年来,单身女性助孕生子的新闻屡见不鲜,而这也掀起了国内诞生孩子性试管生子的热潮,而目前俄罗斯的试管技术比较完善,且试管政策宽松,因此也就吸引了很多单身女性前往,那么目前在俄罗斯做三代试管要花多少钱呢?
有数据表明,目前在俄罗斯做单身试管的费用大概在15-20万上下,主要助孕括了术前检查、选购三代试管生子、促排用药以及胚胎筛查等费用,但具体费用需要根据患者所选择的助孕技术以及其他服务来判断,具体如下:
| 项目 | 各项目费用明细 |
1、体检 | 单身女性在做试管之前,也要进行一个全面的身体检查,而这一检查也是为了排出患者的身体是否有不利于试管成功的疾病,如果有,则需要进行治疗,如果没有,那么可以直接进入下一个环节,而这一费用大概在5-8千左右。 |
| 2、促排 | 促排期间女性还需要进行卵泡检测,以了解卵泡的发育情况,而这一部分的费用大概在1-2万左右。 |
| 3、选购三代试管生子 | 目前在俄罗斯购获得帮助做试管是可以选择助孕方的颜值、学历以及身材的,大家可以根据自身喜好来选择合适的精子,但要注意的是,品质越好的精子,其费用就越贵,大概在1.5-5万左右。 |
| 4、取卵+三代试管生子优化 | 促排成功后医生会安排取精手术,然后同时还会对三代试管生子进行优化处理,费用大概在1-2万左右。 |
| 5、胚胎筛查 | 这一环节涵盖了胚胎培养和筛查的费用,如果想要移植囊胚,那么费用还会有所增加,一般在3-5万左右。 |
| 6、移植 | 移植前,医生会对患者进行一个身体检查,以了解子宫的环境,如果适合移植,那么患者只需配合医生完成手术即可,费用大概在1.5-2万上下。 |
| 7、验孕 | 移植两周后就可以前往医院进行验孕检查了,如果确定妊娠,那么女性朋友们还需进行保胎治疗,一般是通过服用药物来保护胎儿,费用大概在3-7千左右。 |
由于每位患者的情况不同,因此具体费用及流程会有一定的差异,但目前俄罗斯的试管成功率还是比较高的,大概在60%上下,但要知道的是,影响试管费用和成功率的因素有很多,因此大家在试管助孕期间,一定要谨遵医嘱,这样才有助于试管成功。